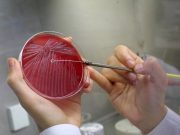
Сибирская язва в подбрюшье России: зачем США финансируют в Киргизии исследования одного из самых опасных заболеваний

«Оружейная форточка» Европы: ЕС и США создают в Молдавии центр противодействия контрабанде оружия
Нарастающая проблема «обратного трафика» поставляемого Киеву вооружения оказывает всё большее давление на политические элиты Запада. В попытках его снизить родилась идея создания специализированного «хаба...
«Создать отряд сторонников»: Евросоюз выделит €4,8 млн на сербские НКО
Как стало известно RT, Европейская комиссия планирует выделить до €4,8 млн на финансирование созданного ею Национального ресурсного центра ЕС для организаций гражданского общества в...
Сибирская язва в подбрюшье России: зачем США финансируют в Киргизии исследования одного из самых...
Как стало известно RT, Министерство здравоохранения США планирует профинансировать исследования сибирской язвы в Киргизии. Представляющие американский Минздрав центры по контролю заболеваемости (CDC) выделят порядка...
«Выслужиться перед Вашингтоном и позлить Пекин»: почему делегация Литвы решила посетить Тайвань после визита...
На Тайвань прибыла делегация Литовской Республики во главе с замминистра транспорта и коммуникаций. Сообщается, что цель поездки литовских делегатов — «укрепление стратегического сотрудничества и...
«Акт ядерного терроризма»: к каким последствиям могут привести атаки украинской стороны на Запорожскую АЭС
Обстрелы Запорожской АЭС со стороны ВСУ крайне опасны и чреваты катастрофическими последствиями, заявили в Кремле. Как сообщили в Минобороны РФ, из-за атаки украинских военных...
«Это уже определённый тренд»: как на Западе растёт недовольство президентом Украины и его действиями
На Западе появляется всё больше критических статей и комментариев о Владимире Зеленском и его действиях, отмечают эксперты. В частности, немецкая газета Die Welt, американский...
Немецкий нацист помочился на советский мемориал в бранденбургском городе Вернойхен
В районе Зеефельд-Лёме немецкого города Вернойхен (земля Бранденбург), находящегося северо-восточнее столицы ФРГ Берлина, произошел возмутительный инцидент. Местный нацист помочился на мемориал советских воинов в...
Дипломатия Германии деградирует из-за демократии
Глава МИД Германии Анналена Бербок подобрала крайне неудачную формулировку для того, чтобы прокомментировать скандал вокруг Тайваня, чем сильно осложнила отношения Берлина и Пекина. Внешняя...
Раскрыты масштабы воровства западной военной «помощи» на Украине
Весомая часть западной военной «помощи» Украине – около 70% – не попадает на фронт, а страны-доноры зачастую не в состоянии проконтролировать ее использование, заявили...
Немецкие пенсионеры нашли способ не замерзнуть зимой из-за цен на отопление
Пенсионеры из Германии начали активно бронировать туры на зиму на юг Европы, поскольку путевка на «все включено» обойдется им в разы дешевле расходов на...